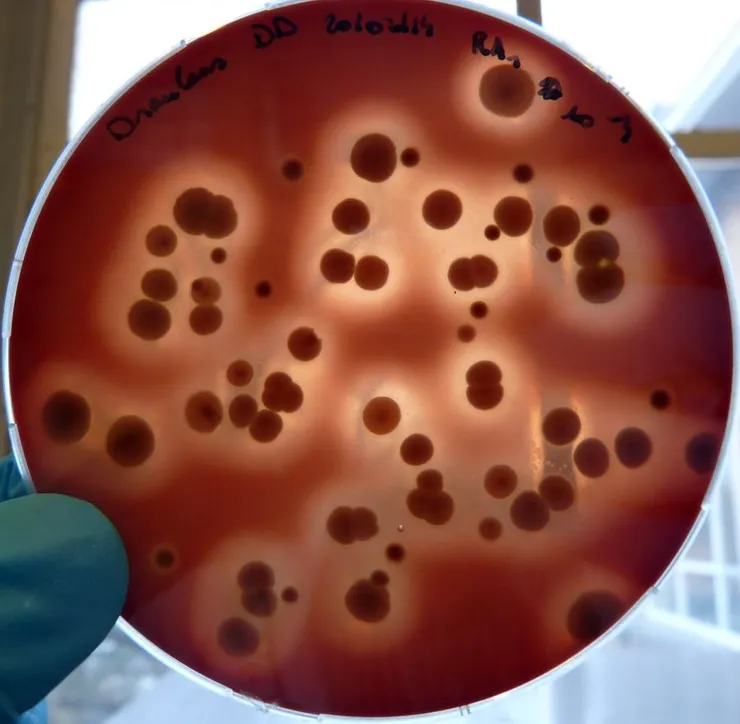
vocus｜新世代的創作平台

天氣熱到不行,大家都可以聞到彼此身上濃縮的怪味道。尤其是坐電梯內,公車內,捷運內...人們身體的氣味,自然的發出,大家戴著口罩😷,假裝不知道🤷♂️,但是也有些人的體香洋溢吸引了你。這些都和你的「腋下」如何,真的很有關係,今天記錄一下吧!
1.您腋下充滿了淋巴結

2.您腋下汗腺和皮膚汗腺不同

實際上,皮膚有兩種類型的汗腺,可以幫助您身體降溫:【外分泌汗腺】(eccrine sweat glands,又稱為小汗腺)和【頂漿腺】(apocrine sweat glands,又稱為大汗腺)。外分泌腺,覆蓋了您身體的大部分皮膚表面,並在熱量和運動過程中,造成額頭和四肢稀薄的汗水。但是,您腋下窩中富含頂分泌腺(也存在於腹股溝中)。這些頂漿腺在毛囊較多的地方很多(腋下、生殖器、肛門四周),分泌的汗液,也往往更濃稠了。
3.您腋下是細菌天堂

我們知道皮膚上有著許多不同種類的細菌,其中有些細菌非常有益,統稱為人類微生物群系(Human microbiome)又稱為「正常菌群」(Normal Flora)。正常菌群在生物體的特定部位生長後,對其他的菌群有生物拮抗的作用。正常菌群(Normal Flora)會隨身體部位的不同而變化。因此,您的腋窩常常夾住,一直處於又暗、又潮濕、又溫暖,這樣環境可能會使正常菌群(Normal Flora)受不了。再加上除了汗液的分泌、又分沁一些油脂油膏,您腋下[油油水水],根本是許多細菌的天堂。與我們皮膚的其他部位相比腋窩的細菌密度更高。
順便提一下,,您腋下細菌微生物群因人而異。 因為有研究對九個人腋下進行採樣後,發現腋窩下細菌群落共有三種類型:一種是由β-變形菌(Betaproteobacteria) 主導,第二種是由棒狀桿菌(Corynebacterium)佔據,第三種是由葡萄球菌(Staphylococcus)佔據。因此《一個人的腋下細菌不一定與 別人的相同》。
4.您腋下臭的不是汗水

您腋下分泌的汗水不會發臭。但細菌會分解這些化合物,而那些分解的產物才會引發臭味。 您腋下汗液中的[油油膏膏]含有揮發性「脂肪酸」和有氣味的「類固醇」(以及其他化合物),這些油膏是細菌的天菜。
在2015 年,約克大學科學家發現形成人體臭味的細菌。他們知道汗液本身是無味的,但是他們發現當細菌在汗液中吞噬含糖蛋白質,會在該過程中釋放一種叫做硫醇 (thioalcohols) 的臭味化學物質,這種氣味不受人們歡迎。
硫醇(thioalcohols)是非常刺鼻,即使只有一點點——一滴水的萬分之一,都會產生惡臭氣味。如果您在高峰時間曾被困在擁擠的電梯,地鐵或健身房中,那麼您可能會熟悉這種洋蔥味,肉味的氣味, 不過《我們俗稱不叫硫醇、而叫「汗臭」或「狐臭」》
5.為什麼小孩子腋下臭味不明顯?

你們一定喜歡抱小孩然後聞小孩身上的味道。有沒有發現其實小朋友身體的臭味,並沒有像大人那麼的明顯,那究竟是為什麼呢?
孩子(大約在更晚的時候)在八歲左右開始「腎上腺[皮質]機能」(adrenarche)初現的過程,也就是腎上腺開始分泌「雄性激素」(androgen)。這些通常是男性荷爾蒙(male hormone),男孩和女孩都有,只是所產生的數量不同而已。進入青春期後,不僅汗水開始散發出刺鼻的惡臭,孩子們也可以開始在腋窩和腹股溝長出毛髮,開始有了明顯臭味了。
6.男女腋下味道各不同

來自日內瓦的叫Firmenich公司的研究人員,為要了解人體氣味的細微差別,以便更好向消費者銷售其除臭產品。 結果他們於2009年在《化學感官, Chemical Senses》發表研究,他們發現您獨特的味道,具體取決於您是,男性還是女性。
女生 : 汗液中含有較高含量的無味的含硫化合物,當與腋下細菌結合時,會產生刺激性的洋蔥硫醇。 所以有時女生經過,偶爾你會聞到"女人味"呀!

男生 : 汗液中所含脂肪酸的含量較高,當腋下細菌接觸該脂肪酸時會產生“ 起司”的氣味。所以有時男生經過,偶爾你會聞到"男人味"呀!

7.動物以腋下吸引性伴侣

亞利桑那州立大學 (Arizona State University)2013年研究, 動物利用腋下和腹股溝的汗水和細菌「發出的化學信號,是專用來吸引些伴侶」。 研究中也冩:如果腋下和腹股溝汗水和細菌發出的化學信號,是專用來吸引些伴侶,在人類也確實存在,但是身為“高文明”的人,不同於野生動物,我們一直相信尋找伴侶的過程,是在於我們的心靈,而不是我們男女彼此的腋窩味道。"
我看完了,一直在暗笑了!
在夏季,熱天氣,使我們的彼此氣味更暪不住了,日常生活中,你有沒有好好清洗腋下呢? 下次出門前,請想想,你的‘腋下’如何了?以免失禮喔!

如果你已經看到最後,可以免費支持我,幫我按下方的【拍手五下】,讓我有機會獲得內容創作的酬勞喔,創作不易啊~























